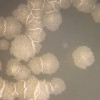

Завтра Луцька громада прощатиметься з Героєм Юрієм Клевцем
Сьогодні 19:05
Сьогодні 19:05
У Луцьку нетверезий 19-річний водій на Mercedes наїхав на пішохідне огородження та втік
Сьогодні 18:46
Сьогодні 18:46
У Запоріжжі бомби впали на пляж, постраждали діти
Сьогодні 18:27
Сьогодні 18:27
На Волині під час купання загинув підліток
Сьогодні 18:08
Сьогодні 18:08
Збитків на понад мільйон: на Волині майора підозрюють у недбалості при закупівлі харчів для військових
Сьогодні 17:33
Сьогодні 17:33
Збільшення виплат і справедлива ротація: луцькі депутати підготували звернення на підтримку війська
Сьогодні 17:16
Сьогодні 17:16
На Волині попрощалися з воїном Олександром Шевченком
Сьогодні 16:44
Сьогодні 16:44
Загорівся очерет: рятувальники загасили берег Світязю
Сьогодні 16:27
Сьогодні 16:27
ССО уразили два ключові заводи росіян поблизу Оренбурга
Сьогодні 16:11
Сьогодні 16:11